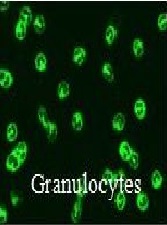
Re-Evaluating the Current ANCA Screening Method: Multiplex Indirect Immunofluorescence Assay in ANCA Testing

Oropharyngeal Invasive Papillary Intralymphatic Angioendothelioma (Dabska’s Tumor): About an Unusual Location of an Exceptional Tumor
Hafsa Elouazzani, Fouad Zouaidia, Sabrine Derquaoui, Ismail Boujida, Hicham Belghiti, Soundous Alrajab, Sophia Nitassi, Leila Essakalli, Nadia Cherradi
International Journal of Clinical Pathology and Diagnosis
Chordoid Glioma of Third Ventricle: About an Extensive and Rapidly Progressive Presentation
Hafsa Elouazzani, Sabrine Derquaoui, Hicham Belghiti, Ismail Boujida, Yasaad Ouadghiri, Zakaria Chandide Tlemcani, Yassir Arkha, Abdessamad Elouahabi, Nadia Cherradi
International Journal of Clinical Pathology and Diagnosis
Primary Effusion Lymphoma with Extracavitary Presentation and A T-Cell Immunophenotype: A Potential Diagnostic Pitfall
Adam Stelling*, Hongying Tina Tan, Martina Zalom, Sheeja T Pullarkat
International Journal of Clinical Pathology and Diagnosis
A Rare and Unexpected Pulmonary Tumor in a Young Woman
G. Boulle, M. Dupeux, M.C. Charpentier, F. Larousserie, J.F. Régnard, D. Damotte, A. Mansuet-Lupo*
International Journal of Clinical Pathology and Diagnosis
Indexes of the Redox State of Blood in Patients with Breast Cancer of Different Hormone Receptor Status
Anatolii Burlaka*, Anastasiia Vovk, Irina Ganusevich, Ihor Motuzyuk, Oleg Sidorchuk, Sergii Lukin, Sergii Virkо
International Journal of Clinical Pathology and Diagnosis
Granular Cell Type of Ameloblastoma: A Case Report
Gholamreza Jahanshahi*, Elham Arzhang, Soheila Derisavy
International Journal of Clinical Pathology and Diagnosis
Endogenous Intoxication of Oligoether in Experimental
Gramatiuk Svetlana*, Bagmut Irena
International Journal of Clinical Pathology and Diagnosis
Epidermolysis Bullosa Nevi -A Concept of Awareness
Vessel Kantarjiev, Todor Yordanov, Valentina Broshtilova*
International Journal of Clinical Pathology and Diagnosis
Somatic Tumors Arising in Ovarian Teratomas-Experience from an Oncology Center in South India
Indu R Nair*, Rajanbabu Anupama, Prasad Chaya, Sreedhar Sarala
International Journal of Clinical Pathology and Diagnosis
Hepatoblastoma andImmunohistochemistry (IHC) Indicators
Naomi Grimminck, MHS, PA(ASCP)CM*
International Journal of Clinical Pathology and Diagnosis
Didelphys Uterus Associated to Ipsilateral Vaginal and Renal Agenesis in Mother of Two Kids: Unusual Case Report
Hafsa Elouazzani*, Ydou Salah, Fouad Zouaidia, Ahmed Jahid, Amine Saouli, Kaoutar Znati, Zakiya Bernoussi, Najat Mahassini
International Journal of Clinical Pathology and Diagnosis
Placental Site Trophoblastic Tumor Reveled by Uterine Arterio-Venous Malformation in Post-Menopausal Women: An Uncommon Case Report Usually Misdiagnosed
Hafsa Elouazzani*, Otman Zahdi, Fouad Zouaidia, Ahmed Jahid, Kaoutar Znati, Abbes Elmesnaoui, Zakia Bernoussi
International Journal of Clinical Pathology and Diagnosis
The Challenges of Bone Marrow Biopsy in Diagnosing Multisystem Langerhans Cell Histiocytosis
Rana Naous*, Mary K. Allen, Sylva Bem
International Journal of Clinical Pathology and Diagnosis
Accuracy of Fine Needle Aspiration (FNA) of the Thyroid in Identifying Papillary Carcinoma in Liquid-Based Cytology
MW Mourad, WA Mourad*, DG Fontaine, M Dvorakova, R Whaghray, A Abdulla
International Journal of Clinical Pathology and Diagnosis